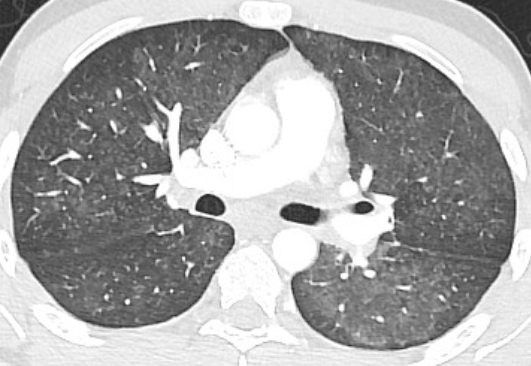
lung-dr | 呼吸器内科医 tweet media

lung-dr | 呼吸器内科医
2.7K posts

@lungdrnote
🫁呼吸器内科・総合内科・アレルギーの専門医、医学博士 / ガイドライン・論文の解説、クイズ、専攻医A、研修医BとC / お気軽にフォロー/ 過去スライドはハイライト / 🐈 #猫 / ブログへ👇/ 週前半は実験的投稿頻度増、半ば以降にお勉強系投稿。

教えて教授! Q. 呼吸器内科ローテで言っちゃいけない言葉ってありますか? (24歳男性、新研修医) 教授「呼吸苦」

教えて教授! Q. 呼吸器内科ローテで言っちゃいけない言葉ってありますか? (24歳男性、新研修医) 教授「呼吸苦」


【解答・解説】 Good症候群 🦁「反復する感染症に加えて低ガンマグロブリン血症、さらに前縦隔腫瘤があれば胸腺腫関連の免疫不全を疑おう!」 Good症候群は胸腺腫と低ガンマグロブリン血症が合併する成人発症の免疫不全症である。IgG・IgA・IgMといった免疫グロブリンが低下するため抗体産生能が障害され、肺炎球菌やインフルエンザ菌などの莢膜細菌による呼吸器感染症を繰り返しやすくなる。さらにB細胞の著明な減少やCD4陽性T細胞の低下を伴うこともあり、液性免疫だけでなく細胞性免疫にも異常を認める複合免疫不全の性質を持つ。そのため細菌感染だけでなく、カンジダやCMVなどの日和見感染を合併することもある。 本症例では肺炎球菌感染を繰り返していることに加え、血液検査で低ガンマグロブリン血症が確認されており、さらに胸部画像で前縦隔腫瘤が示唆されている。胸腺腫と低ガンマグロブリン血症の組み合わせはGood症候群を強く示唆するため、本疾患を最も疑う。

──救急外来から電話── 研修医「コンサルトお願いします! 59歳男性、主訴は発熱…」 指導医「…」 研修医「既往は糖尿、内服は…」 指導医(プレゼン……丁寧だ。長いけど) 研修医「血圧66/40」 指導医「今行く!!」
